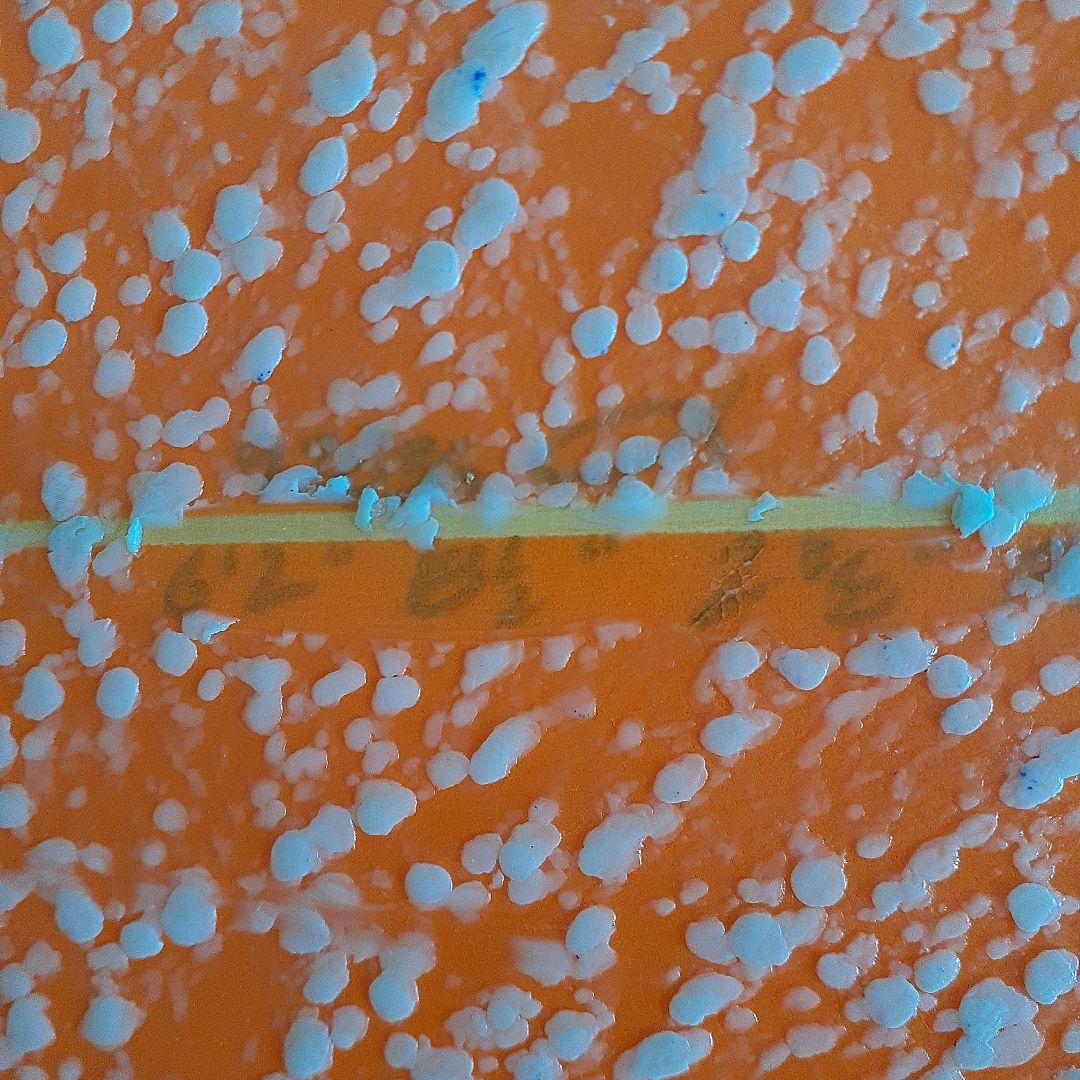
アルメリック　フライヤーⅡ　6.2

マイストア
変更
お店で受け取る
(送料無料)
配送する
納期目安:
2026.04.23 6:30頃のお届け予定です。
決済方法が、クレジット、代金引換の場合に限ります。その他の決済方法の場合はこちらをご確認ください。
※土・日・祝日の注文の場合や在庫状況によって、商品のお届けにお時間をいただく場合がございます。
アルメリック フライヤーⅡ 6.2の詳細情報
Flyer 2(フライヤー 2) モデルは、チャンネルアイランドのラインナップの中でも人気の高いオールラウンドモデルです。Flyerモデルのコンセプトを参考に、レールを多少薄くしてコントロール性能を高めて、コンケイブを深めに入れる事によってスピード性とルース性を高め、細く絞られたスワローテールは頭オーバーの波でも安定感を与えています。美品 FCS2 ロブマチャド キールフィン。このモデルは、アルメリックのラインアップの中でもっとも多彩多芸なオールラウンド・モデルと考えらています。AVISO Gold Label CANVAS ミニノーズライダー 5’12”。HAP JACOBS ロングボード 9`6f 美品 3ストリンガー。デッキ、ボトム共にノーズにステッカー剥がした跡の影があります 写真参照写真のフィン付きます千葉一宮で手渡し希望
ベストセラーランキングです
近くの売り場の商品
カスタマーレビュー
オススメ度 4.8点
現在、4948件のレビューが投稿されています。